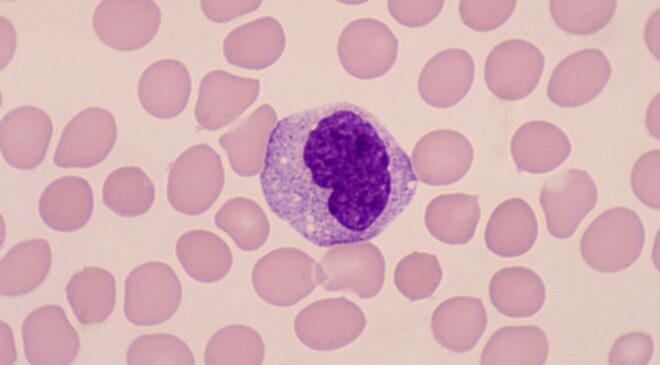

Nel contesto delle immunoterapie ematologiche innovative, spesso caratterizzate dall’insorgenza di complicanze iperinfiammatorie, il laboratorio riveste un ruolo sempre più strategico nel supportare il processo decisionale clinico. È quanto emerge dal contributo scientifico presentato da Giovanni Riva, Diagnostica Ematologica, Dipartimento di Medicina di Laboratorio e Anatomia Patologica dell’AUSL/AOU di Modena, al congresso internazionale ISLH 2026 (International Society for Laboratory Hematology), tenutosi a Edimburgo dal 17 al 19 aprile.
Nel suo intervento, il dottor Riva ha mostrato come un parametro avanzato dell’emocromo, l’MDW (Monocyte Distribution Width), possa fornire informazioni clinicamente rilevanti a supporto di una gestione più informata e consapevole del paziente ematologico complesso sottoposto ad immunoterapie innovative.
Dall’analisi dei dati preliminari di uno studio in corso, emerge infatti che le variazioni dell’MDW presentano una coerenza biologica con lo stato di attivazione dei monociti circolanti nel sangue periferico. Un aspetto, questo, che può dare un contributo ad una valutazione più dinamica, integrata e contestualizzata del profilo infiammatorio del paziente.
“Il risultato principale del nostro contributo è la dimostrazione che MDW può arricchire l’analisi del profilo infiammatorio del paziente, fornendo al clinico un’informazione aggiuntiva sullo stato di attivazione monocitaria”, spiega Giovanni Riva. “Questo aspetto è particolarmente rilevante nei contesti di ematologia complessa, dove la lettura integrata dei dati di laboratorio è fondamentale”.
Che cos’è l’MDW
L’MDW è un parametro dell’emocromo che descrive la variabilità dimensionale dei monociti e riflette i cambiamenti morfologici e funzionali associati all’attivazione del sistema immunitario. Pertanto, negli ultimi anni, questo parametro è diventato un importante marcatore precoce di sepsi, già validato nel setting del Pronto Soccorso.
A differenza dei tradizionali marcatori flogistici utilizzati per la diagnosi di sepsi – basati sul dosaggio plasmatico di proteine dell’infiammazione – MDW è un nuovo marcatore di tipo citometrico, che valuta i parametri cellulari derivanti direttamente dall’emocromo.
Negli ultimi anni, diversi studi hanno progressivamente ampliato il significato clinico dell’MDW, dimostrando come questo non supporti esclusivamente l’identificazione precoce della sepsi, ma risulti associato anche a sindromi iperinfiammatorie sistemiche non settiche, espressione di uno stato generale di iperattivazione immunitaria non causato da un’infezione.
I dati preliminari presentati al Congresso ISLH 2026 estendono ulteriormente questo concetto a pazienti ematologici trattati con immunoterapie avanzate, come linfociti CAR T e anticorpi monoclonali bispecifici (BiTE), che possono causare una complicanza potenzialmente fatale, caratterizzata da una marcata immunoattivazione sistemica, la cosiddetta Cytokine Release Syndrome (CRS).
“In strutture ospedaliere ad alta complessità, il clinico ha bisogno di nuove informazioni che aiutino a interpretare in modo più completo la condizione infiammatoria sistemica del paziente”, osserva Giovanni Riva, “L’MDW può rappresentare un marcatore utile per la diagnosi ed il monitoraggio prognostico del paziente ematologico che sviluppa la sindrome da rilascio citochinico (CRS), una temuta complicanza associata alle nuove terapie immunobiologiche come cellule CAR-T e anticorpi bispecifici”.
“Queste osservazioni rafforzano il ruolo dell’MDW come nuovo parametro laboratoristico di attivazione immunitaria”, prosegue il dottor Riva, “MDW può completare le informazioni provenienti dagli altri parametri bioumorali, aiutando il clinico a valutare meglio e più rapidamente il profilo infiammatorio del paziente”.
L’impatto operativo dell’MDW sul laboratorio
Un ulteriore elemento di rilievo riguarda l’impatto operativo sul laboratorio: l’MDW è già disponibile come parametro incluso nell’emocromo di routine e non richiede modifiche dei flussi di lavoro né l’esecuzione di un prelievo dedicato.
“Valorizzare i parametri già presenti nell’emocromo significa permettere al laboratorio di aumentare il proprio contributo clinico senza aggiungere complessità”, conclude Giovanni Riva, “È un esempio concreto di come l’ematologia di laboratorio possa supportare in modo sempre più attivo la gestione clinica dei pazienti complessi”.